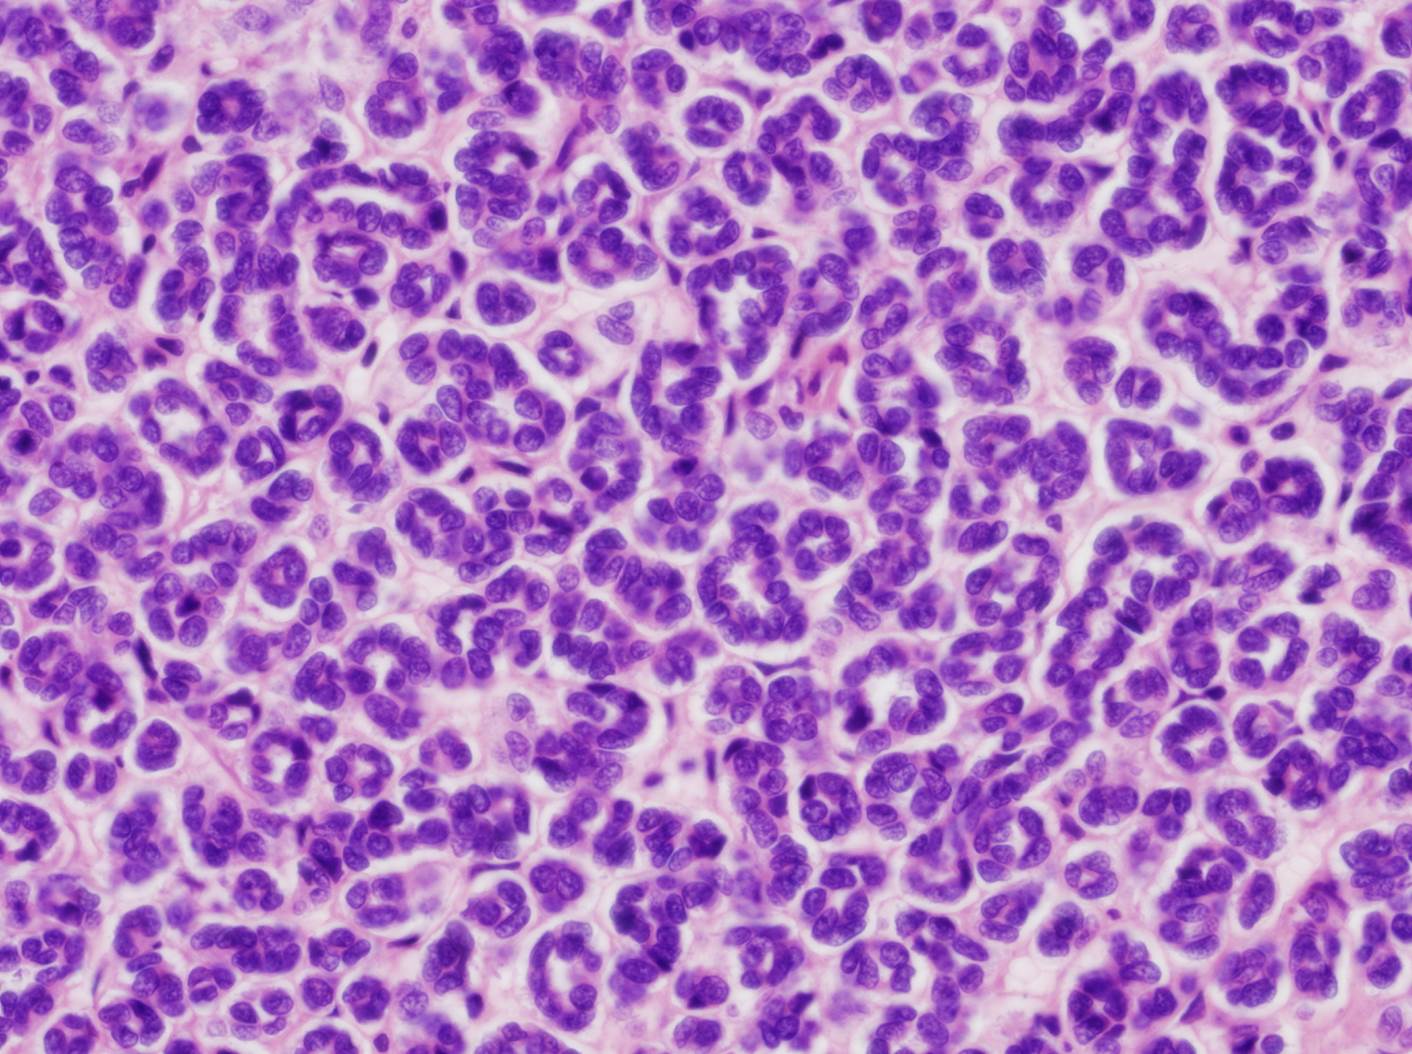

Case ID: 693
Publication date: 18 Jan, 2016
Consensus grade: I would not grade this tumor
Show diagnosis by expert panel members| User | Diagnosis | Difficulty | Comment |
|---|---|---|---|
| Pathologist 1 | I would not grade this tumor | Typical | |
| Pathologist 2 | I would not grade this tumor | Typical | |
| Pathologist 3 | I would not grade this tumor | Typical | |
| Pathologist 4 | I would not grade this tumor | Typical | |
| Pathologist 5 | I would not grade this tumor | Typical | |
| Pathologist 6 | I would not grade this tumor | Typical | |
| Pathologist 7 | I would not grade this tumor | Typical |
metanephric adenoma |
| Pathologist 8 | I would not grade this tumor | Typical |
Metanephric adenoma |
| Pathologist 9 | I would not grade this tumor | Typical | |
| Pathologist 10 | I would not grade this tumor | Typical | |
| Pathologist 11 | I would not grade this tumor | Typical | |
| Pathologist 12 | I would not grade this tumor | Typical | |
| Pathologist 13 | I would not grade this tumor | Typical | |
| Pathologist 14 | I would not grade this tumor | Typical | |
| Pathologist 15 | I would not grade this tumor | Typical |
metanephric adenoma |
| Pathologist 16 | I would not grade this tumor | Typical |
metanephric adenoma |
Case description (by case creator):